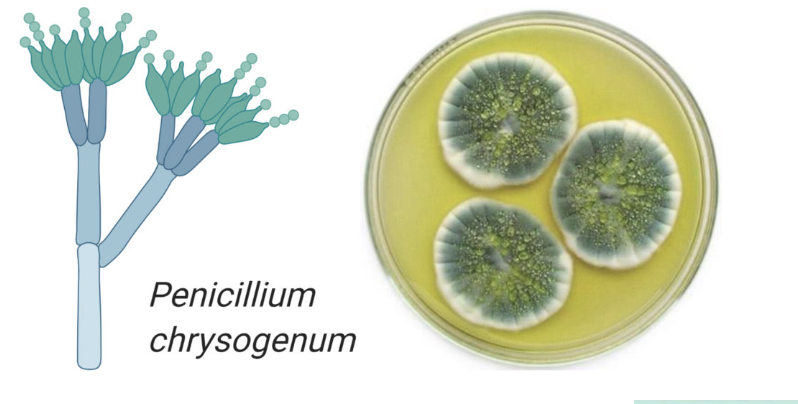
<p></p>
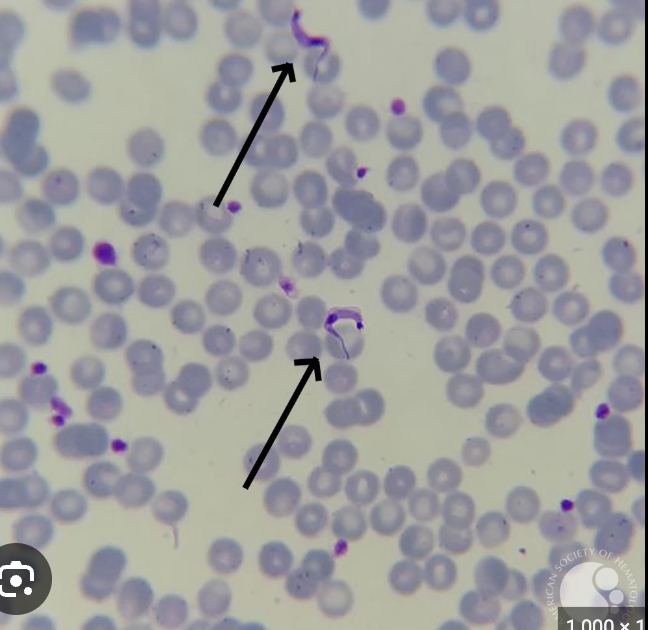
<p><span style="background-color: transparent; font-family: "Times New Roman", serif;">&nbsp;Trypanosoma Cruzi (like crucio)&nbsp; kissing bug</span></p>
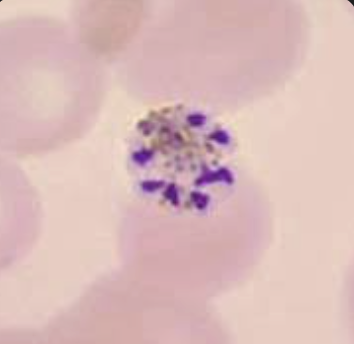

1/79
Looks like no tags are added yet.
Name | Mastery | Learn | Test | Matching | Spaced | Call with Kai |
|---|
No analytics yet
Send a link to your students to track their progress

Merismopedia - a grid-like structure

Anabaena - vegetative cells (Heterocyst is empty ball, Akinete thick dark oval survival structure)

Diatoms - glass like, geometric silica golden brown color sometimes

Dinoflagellates- they kinda look like walnuts 2 flagella + causes red tide Paralytic shellfish poisoning

Red algea- (phycoerythrin) absorbs deep light and multicellular so eukaryotic

green algae- chloroplasts , eukaryotic
what is the function of heterocyst?
nitrogen fixation (no photosynthesis)
what is the function of akinete ?
survival spore for harsh conditions
what is the function of a vegetative cell?
for photosynthesis
Are cyanobacteria prokaryotic or eukaryotic cells?
prokaryotic
do cyanobacteria have a nucleus and organelles?
no nucleus no membrane bound organelles
photosynthesis happens in the thylakoid membranes in cytoplasm
What kinds of pigments do cyanobacteria have?
blue and green
What is the function of a trichome?
chain of cyanobacteria that allows for a passage for nutrient sharing

what is a sheath?
a protective layer around the trichome

What medical issues can dinoflagellates cause?
paralytic shellfish poisoning
what types of cyanobacteria did we see?
merismopedia and Anabaena

what is the study of fungi called
Mycology
are fungi eukaryotes or prokaryotes?
fungi are eukaryotes
are fungi heterotrophs or autotrophs
fungi are heterotrophs (feed on other organisms for energy)
What are the two types of fungi? What are the differences between
the two?
Yeast (unicellular) Mold (multi, grows as long thin strands called hypha)

pseudohypha (candida)

hypha (singular)

yeast
what is a fungal spore? when is it produced?
haploid, single celled, used by fungi to spread, reproduce and survive in extreme environments
what is an example of a zygomycetes?
A sporangium produces spores (reproduction) tip of hypha

what is the Sporangium of Rhyzopus ?


Penicillium chrysogenum (dark, broom like)
Aspergillium (pom pom, looks white like dandelion)

Yeast (budding ovals)

Are protozoan eukaryotic or prokaryotic?
Eukaryotic has membrane bound organelles
Are protozoan unicellular? Multicellular? Both?
Unicellular
How do we classify protozoans?
Type of movement motility
Know the examples given for each type of locomotion
Cyst : non motile , thick walls, dormant (survival outside host contamination stage) think “c” for concrete → not motile
Trophozoite: active, motile, feeding form (causes damage to host)
flagellar swimming, ciliary beating, amoeboid pseudopodia, twitching, gliding, and sliding,
Euglena (flagellate)

Paramecium (ciliate → uses cilia)

ameoba (pseudopods)

what is a cyst?
A closed sac-like pocket of tissue , its dormant , thick walls, non-motile c for concrete not moving
What is a trophozoite?
The feeding stage of a protazoa, active, motile, damages the host inside
Which protozoans have flagella?
Euglena, Giardia, Trypanosoma, Trichomonas

Which protozoans move in an ameboid fashion?
Ameobas, crawling movement
which protozoans are non-motile? which move with cilia?
apicomplexans ; paramecium ciliate
What protozoan causes giardiasis?
Giardia Lamblia

How would you be exposed to that
Protozoan? (giardia lamblia)
Contaminated water
What protozoan causes African sleeping sickness?
Trypanosoma brucei

How do you pick uup African sleeping sickness?
tse tse fly
What protozoan causes Chagas disease?
Trypanosoma Cruzi (like crucio) kissing bug
What protozoan causes trichomoniasis?
STD Trichomonas vaginalis

What protozoan causes malaria?
Plasmodium

How do you pick up malaria?
Anopheles mosquito
Disinfectants
Chemicals used on inanimate obj. (countertops, tables, equipment)
Antiseptics:
Chemical used on living tissue (alcohol wipes, iodine)
Bacteriostatic
“static” inhibits growth but does not kill STOP
Bactericidal
KILLS bacteria “Cida”- suicidal to bacteria
What is a zone of inhibition?
After placing antibiotic discs and incubating, bacteria will not grow near chemicals that work
If a microbe is susceptible to a chemical, is the zone big or small?
Susceptible = BIG zone of inhibition
If a microbe is resistant to a chemical, is the zone big, small or non-
Existent?
Small or NO ZONE (chemical does NOT work)
What is the Kirby Bauer test?
To determine which antibiotic works best
Swab lawn of bacteria on agar dish
Apply antibiotics
Incubate for two-three days
Measure zones of incubation using S,R,I (susceptible: Big ZOI) (resistant: small ZOI) (intermediate: medium ZOI)
For the phenol coefficient test, what was used as a control? What
Percentage?
Phenol is the control used with a 5% concentration
Usually, you measure the diameter for the zone of inhibition, if you
can’t how would calculate the zone?
Measure in mm ; measure the radius by (x2) ; OR take two perpendicular measurements and average it.
Be able to explain how you did the phenol coefficient and Kirby
Bauer test
Phenol coefficient= dilution of test chemical / dilution of phenol
A coefficient greater than 1.0 means the disinfectant is more effective than phenol.
What is a satellite colonies? What do they mean about resistance?
Satellite colonies grow inside zone of inhibition, this means the bacteria are developing resistance
PRSA?
Penicillium-resistant staph aureus
MRSA?
Methicillin-resistant staph aureus
VISA
Vancomycin-intermediate staph aureus
VRSA
Vancomycin-resistant staph aureus
What is a broad spectrum antibiotic?
Broad spectrum works on Gram+ and Gram–
Broad = more side effects (kills normal flora)
Amoxicillins , piperacillin , flurouquinolone,
what is a narrow spectrum antibiotic?
works on specific groups like Gram+ penicillin
= preferred when organism is know
Vancomycin’s , axithromycin ,
What does ELISA stand for?
Enzyme Linked Immuno Sorbent Assay
Explain what the ELISA we did was looking for?
It was used to detect antibodies in the patient’s serum (to see if they were exposed to or infected by a specific pathogen). to see if the pt has antibodies against the disease antigen in the well
If the patient’s serum contained antibodies → they would bind → leading to a positive color reaction.
General steps of ELISA
antigen coated on well → sticks to plastic well → provides the target
add patient serum → antibodies (if present) bind to antigen → detects exposure
add secondary antibody (enzyme linked) → enzyme converts substate color → shows positive result if changes color
What was first bound to the well?
the antigen (from the pathogen)
Then what was bound to the well?
The patient’s antibodies (if present in their serum)
Then what? (after pts serum)
The enzyme-linked secondary antibody → this antibody binds to the patient’s antibody.
What was the substrate?
TMB (Tetramethylbenzidine) is the most common substrate used in ELISA labs.
What was the enzyme bound to?
The enzyme (HRP – Horseradish Peroxidase) was bound to the secondary antibody.
If both the enzyme and substrate were present, what happened?
A color change occurred (usually blue → yellow)
Color = POSITIVE result
No color = Negative (no antibodies present)
What was the positive control? Why?
Serum with known antibodies and proves the test works and should turn color
What was the negative control? Why?
serum with no antibodies and shows what a true negative looks like (no color) without it you wouldnt know for sure if your test was valid
What is the purpose of the wash buffer?
To wash away unbound antibodies so that:
Only specific binding remains
Prevents false positives
(If you don’t wash → everything sticks → all wells turn color)
What was in each well (Row A–D)
Row | Contents | Expected Result |
A | Positive control serum | Should turn color |
B | Negative control serum | Should stay clear |
C | Patient sample 1 | Unknown (positive or negative) |
D | Patient sample 2 | Unknown (positive or negative) |